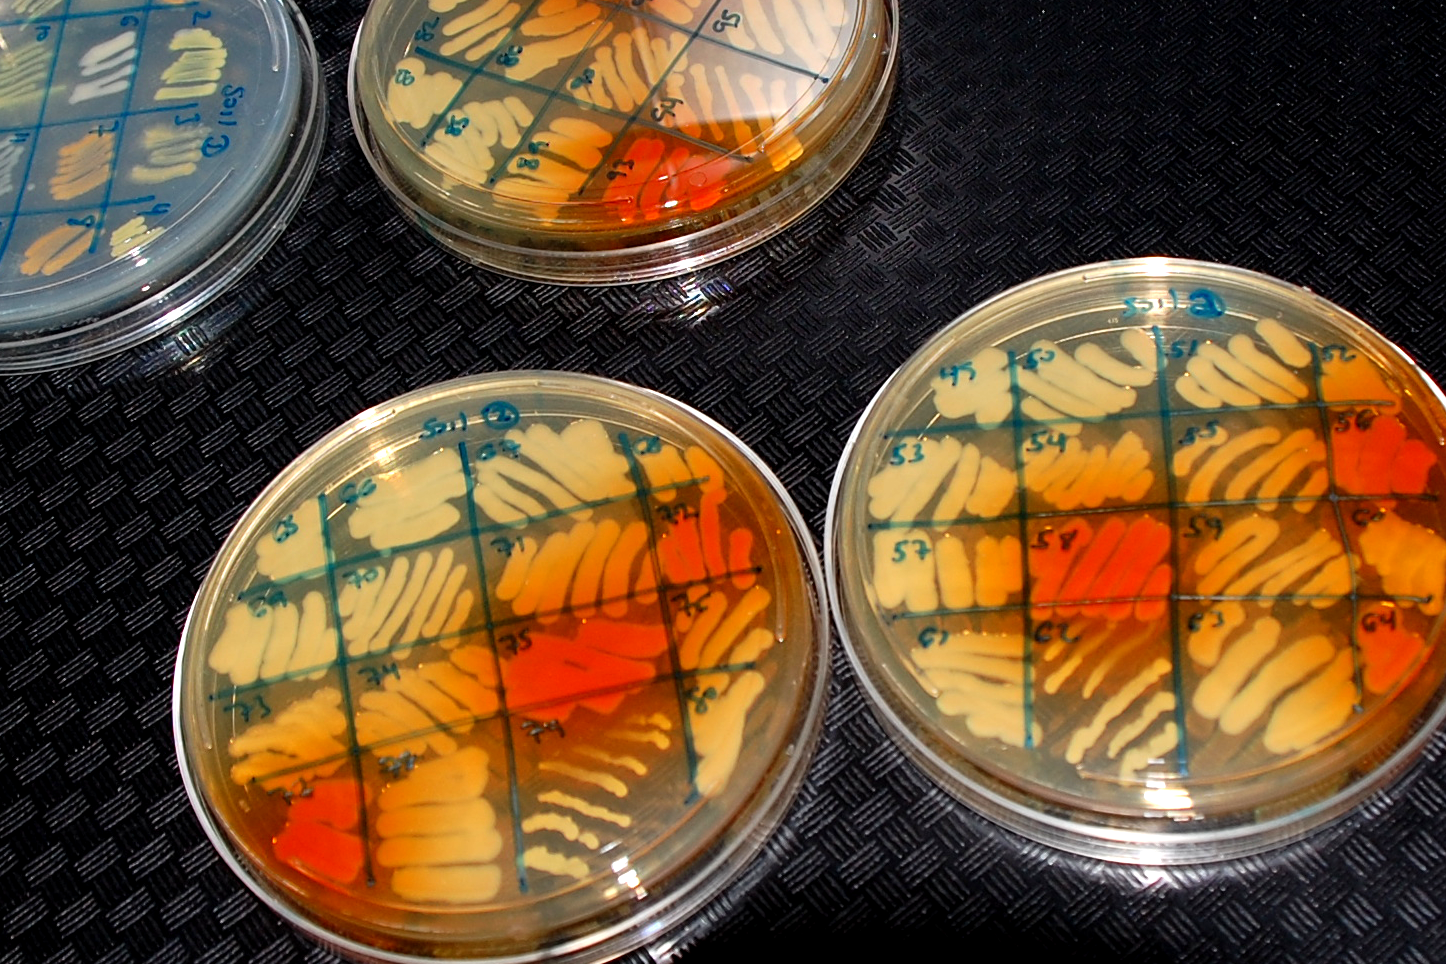

Wisconsin lawmakers are considering ending “gain-of-function” research at all higher education institutions in the state.
The rare practice of modifying risky pathogens to make them more harmful to people during research has become political and controversial since the COVID-19 outbreak.
The GOP-written bill prohibits higher education institutions from conducting this type of research on “potentially pandemic pathogens.”
News with a little more humanity
WPR’s “Wisconsin Today” newsletter keeps you connected to the state you love without feeling overwhelmed. No paywall. No agenda. No corporate filter.
If any school — including a Universities of Wisconsin college, technical college or private or nonprofit institution — does conduct this type of research, funding would be withheld from the institution the following year.
A “potentially pandemic pathogen” is defined in the bill to mean a virus, bacteria, fungus or eukaryotic parasite, or any strain or variant of a virus, bacteria, fungus or eukaryotic parasite.
State Rep. Elijah Behnke, R-Oconto, and Sen. André Jacque, R-DePere, testified on behalf of the bill this week during an Assembly Committee on Colleges and Universities hearing.
Both cited previous incidents at the University of Wisconsin-Madison and the lab leak theory that COVID-19 came from Wuhan, China.
“These are the close calls that we know of. I do wonder about the close calls that we don’t know about,” Behnke said. “If even one incident would result to a spill over to the general population, the results would be catastrophic.”
Behnke said just one lab at UW-Madison is conducting this type of research. But if a person becomes infected, resulting lawsuits could bankrupt the whole Universities of Wisconsin system.
The bill would also require a person to submit a report to the state Department of Health Services at least three months before beginning research on a potentially pandemic pathogen.
If a person or lab does not timely provide a report, they may be required to forfeit no less than $50,000 nor more than $100,000 for each day a report is not provided.
Supporters say bill will limit catastrophic events
Dr. Justin Kinney, an associate professor of quantitative biology at Cold Spring Harbor Laboratory in New York, also testified in favor of the bill. Kinney is the co-founder of Biosafety Now, a New Jersey-based nonprofit.
He said the majority of scientific research is safe and only a small fraction of accidents pose a risk to the public.
But potential pandemic pathogens are viruses and bacteria that, if released, “could spread uncontrollably through the human population and potentially cause a devastating pandemic.”
“Disclosure of this information is essential,” Kinney said. “In the event of a laboratory accident, first-responders and health care providers having this information could well make the difference between rapid pathogen containment and an uncontrolled disease outbreak.”
Medical College, UW-Madison say bill could limit research
The state’s leading research universities, UW-Madison and the Medical College of Wisconsin say the proposal could limit research and innovation being done at the institutions including the development of vaccines.
“Research on potential pandemic pathogens is highly regulated at the federal level,” the schools wrote in a letter to the committee. “While studying pathogens does not come without risk, federal laws, regulations, and guidelines aim to balance the risk of this research with its public health and economic benefits.”
The schools said without being able to do this research, Wisconsin would have to rely on other states’ research.
“The bill would also risk the potential loss of millions of dollars of federal grant funding that benefits the state and its taxpayers and could hamstring the growth of Wisconsin’s biotech and biomedical sectors.”
In November, the U.S. House of Representatives approved a ban on federal funding for gain-of-function research.
Wisconsin Public Radio, © Copyright 2025, Board of Regents of the University of Wisconsin System and Wisconsin Educational Communications Board.